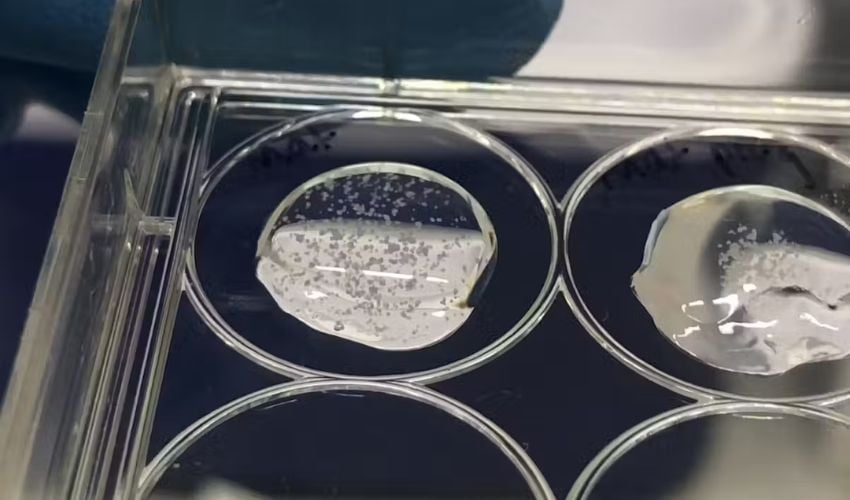

How Bioprinted Mini-Placentas Could Help Us Understand Pregnancy Complications
Placentas are a small but mighty organ, with many unique traits. It’s the only organ that is “disposable,” and a new one begins to form each time a fertilized egg is implanted in the uterus. Then, they grow rapidly in conjunction with the fetus, and can become the size of a small plate. This humble organ is literally a baby’s lifeline: babies don’t breathe or eat in the womb, so the placenta acts as their oxygen and nutrient supply, as well as the baby’s kidneys, which filter out waste from the bloodstream.
Although the placenta is critical to fetal development, it remains one of the least understood organs in human biology. One reason is that it is difficult to obtain samples during pregnancy without risking complications such as infection or miscarriage. After birth, the tissue changes significantly, making it unsuitable for studying early placental development. Animal models provide limited insight because most animal placentas differ substantially from those of humans. As a result, researchers still lack a clear understanding of how the placenta develops and functions, particularly in the early stages of pregnancy.

A placental organoid under the microscope
Placental Organoids
By 3D printing artificial mini-placentas, called organoids, researchers from the University of Technology Sydney are trying to fill this gap in understanding. Organoids, which arrived on the medical scene in 2009, are created by suspending stem cells in a gel that allows them to form clusters as they grow and divide. In 2018, researchers created the first placental organoids using trophoblasts, which are a cell type only found in the placenta.
By growing placental organoids, researchers can study crucial processes in early pregnancy, hopefully discovering the causes of serious conditions like preeclampsia. Pre-eclampsia is linked to placenta dysfunction, and it affects 5-8% of pregnancies. The condition causes a staggering 46,000 maternal deaths and around 500,000 newborn deaths every year, and even when it is not fatal, it causes high blood pressure and can damage organs. Furthermore, it can lead to early delivery and harm mothers and babies in various ways. The only current cure for pre-eclampsia is delivery, because scientists don’t know what causes it.
While there have been efforts to study the placenta through placental organoid studies, most of these have relied on suspending torphoblasts in animal-derived gels. These gels do not accurately reflect the growing environment of an actual placenta. Plus, it is cumbersome to manually suspend cells to create many organoids.
Why Bioprinting?
The placental organoids developed by the University of Technology Sydney are significant because they are the first ones to be bioprinted. Additionally, they were made with a mix of trophoblast cells and a synthetic, controllable gel, rather than an animal-based one.
These organoids grew differently compared to those made in animal-derived gel, developing a different number of cell sub-types. Claire Richards and Lana McClements, co-authors of the study, wrote about their research results for The Conversation: “These organoids were very similar to human placental tissue, providing an accurate model of the early placenta,” they wrote. “We could change how the cells organised themselves by taking young organoids out of the gel and letting them float in their liquid food.”

Bioprinters are advantageous because they allow cells to be positioned precisely in a 3D structure
Potential Applications
Placental organoids like the ones developed in this study can help researchers better understand pregnancy complications and test new drugs safely. The Sydney researchers, for instance, did an experiment where they exposed the organoids to an immune signal that had a high presence in women with pre-eclampsia. Then, they tested different treatments to see how the organoids responded.
Going forward, tools like CRISPR could edit genes in cells and better understand how the process works. Additionally, the organoids could be used to examine infections, and test drugs for safety and effectiveness. With bioprinting, scientists can improve the accuracy and repeatability of their experiments, and reduce the need for animals in research. This technology can play a pivitol role in predicting, preventing and treating pregnancy complications. To learn more, read the full article HERE.
What do you think of the 3D printed placenta? Let us know in a comment below or on our LinkedIn or Facebook pages! Plus, don’t forget to sign up for our free weekly Newsletter to get the latest 3D printing news straight to your inbox. You can also find all our videos on our YouTube channel. Interested in more medical and dental 3D printing news? Visit our dedicated page HERE.
*Cover Image: Organoids suspended in gel, ready to slice and view under the microscope. All Photo Credits: Claire Richards






